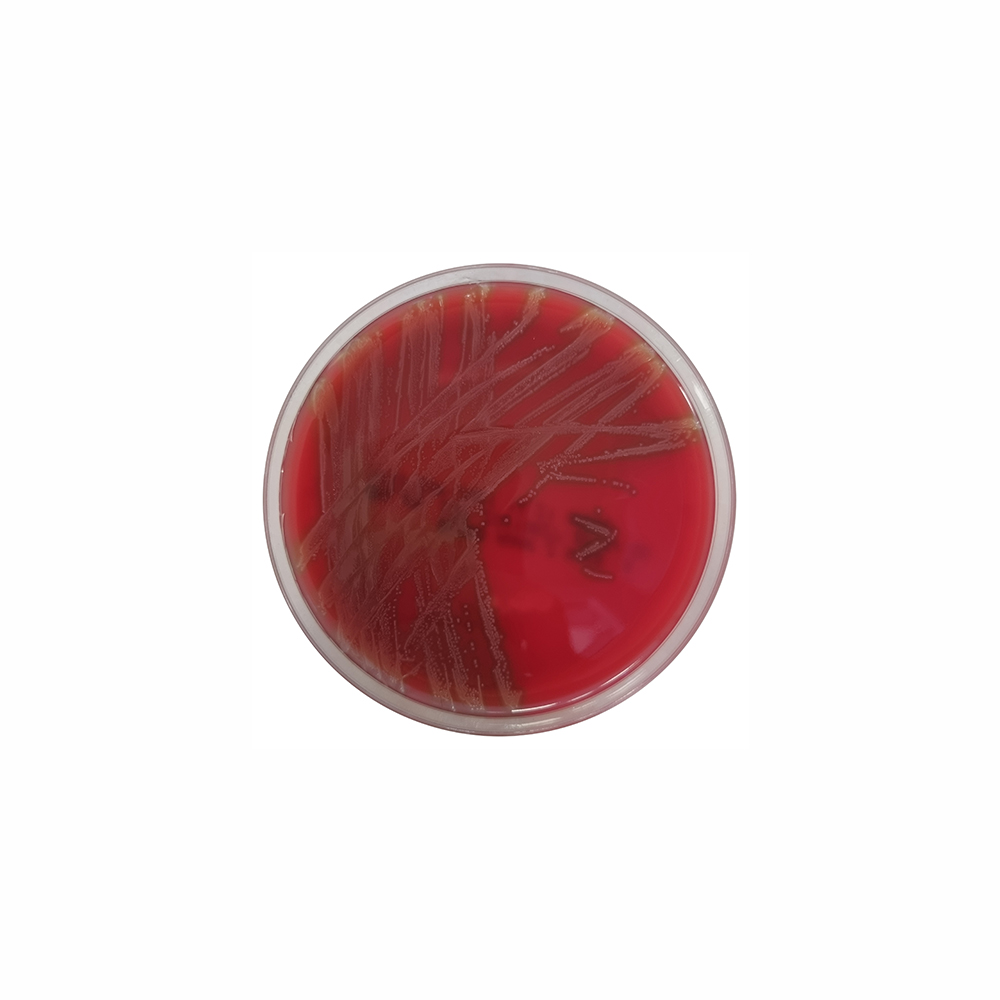
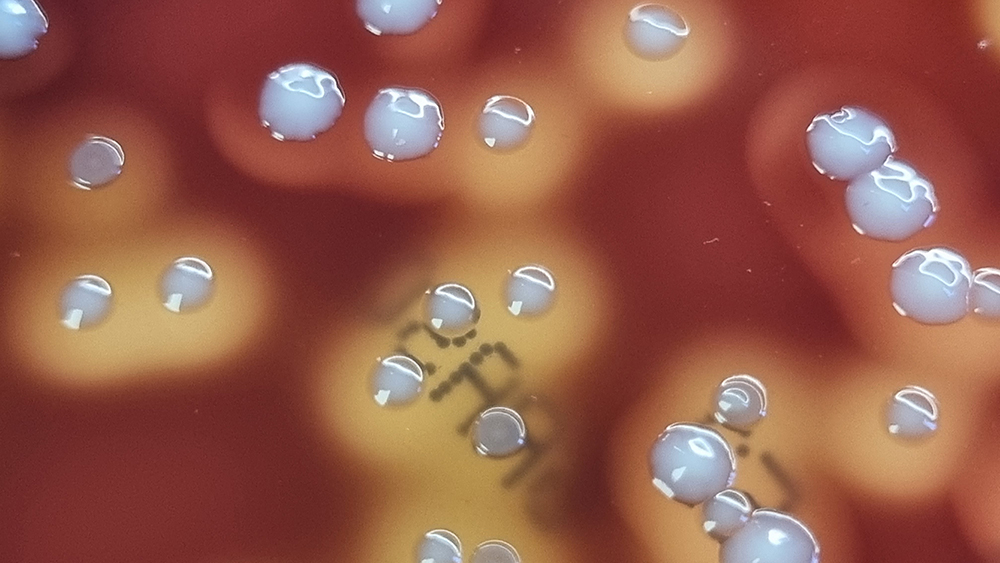

Über das Produkt
Fertigplatten zur selektiven Isolierung von grampositiven Kokken.
Ähnliche Produkte
Columbia-Agar mit 5 % Schafblut, Fertigplatten
Columbia-CNA-Agar mit 5 % Schafblut, Fertigplatten

Fertigplatten zur selektiven Isolierung von grampositiven Kokken.
Columbia-Agar mit 5 % Schafblut, Fertigplatten